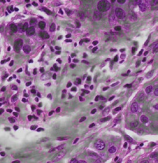

PT Wadya Prima Mulia as the Exclusive Distributor for Evident-Olympus in Indonesia, provides Color Microscope Camera EP50 and other products.
Wireless Digital Imaging
Convert each microscope into a wireless imaging system and enhance collaboration in the classroom.
Inspiring Enthusiasm
Breaking away from static microscope labs, the EP50 camera and WLAN adaptor can transform the classroom into a dynamic, interactive space.
- Flexible camera control and viewing options: connect using mobile devices or WLAN-enabled PCs/laptops via wireless or wired LAN connection
- High-quality, crisp, 5-megapixel images
- Fast frame rates enable students to navigate quickly through the specimen
Interactive Learning
The flexible camera control and viewing options offered by the complimentary EPview app software expand interaction and collaboration possibilities:
- Control the EP50 camera using the EPview app for mobile devices or software for PCs/laptops (see specs for version compatibility)
- Up to 6 users can connect their devices to the same WLAN-enabled EP50 camera
- Access the images of other EP50 cameras in the classroom
- Capture, process, store, and share the EP50 camera’s images through the easy-to-use software interface
- Simultaneous live image output via WLAN and HDMI
Engaging Lectures
Lecturers and students can both benefit from the image sharing, viewing, and storage options of the EP50 WLAN-enabled camera:
- Live stream images to a group of students on their mobile devices or WLAN-enabled PCs/laptops
- Display specimen images on a high-resolution monitor, projector, or interactive white board connected to the camera’s HDMI port
- Present Full HD videos
- Connect an SD card and save captured image data for further analysis
Improved Learning Process
Students can experience a digital-image-supported learning process:
- Students can work comfortably, on their own or in collaboration, using the camera’s On-Screen Display (OSD) imaging software
- The OSD software is simple and intuitive
- Easily capture, view, and process specimen images and movies
- Save observation data for further investigation on an SD card
Easily Capture Digital Microscope Images
- Olympus Smart Image Averaging (OSIA) suppresses noise and eliminates artifacts while maintaining a fast frame rate
- Focus peaking helps you identify which sample regions are currently in focus
- High contrast mode enables easier image acquisition with a high signal-to-noise ratio so that you can capture high-quality images from dim samples during polarization and fluorescence microscopy
- Fast live function provides a consistently high displayed frame rate during long-exposure imaging
Simple-to-Use Camera
- Thoughtfully designed software enables you to acquire images with just a single click for an efficient workflow
- Attach the camera’s standalone module to the back of your monitor to free up valuable desk space
- Plug the camera into your computer’s USB 3.1 port*, and it’s ready to use—no separate AC adaptor required
* USB 3.1 Gen is compatible with USB 3.0.
Digital Classroom
A WLAN-enabled Olympus EP50 camera is capable of creating its own wireless network or it can be integrated into LAN networks using its USB-to-Ethernet adaptor, providing flexible classroom configuration options:
- Through a WLAN connection, students can control the camera using the EPview software and observe and present digital images from their microscopes
- Teachers and students can directly access live microscope images, making the classroom a truly interactive space
- Through a LAN network with a router and using the EPview app software, entire classrooms can view a camera’s images on their mobile devices or WLAN-enabled PCs/laptops
PC/Laptop-Powered Learning
Users with WLAN-enabled PCs and laptops with Windows operating systems can download and install the free EPview software.
The EPview software for PCs/laptops offers the same camera-control and functionalities as EPview for mobile devices, including viewing, capturing, processing, saving, and sharing the acquired images and movies.
Share Images on Monitors or Projectors
Use the HDMI port to connect the camera to monitors and projectors to display and share live or previously captured images. Sharing 60 fps Full-HD live images or videos can transform the microscopy classroom from an individual experience into an engaging group activity. Simultaneous output through both WLAN connection and HDMI is available.
Stand-Alone Mode
With only a monitor and a USB mouse, users can control the EP50 camera using its On-Screen Display (OSD) software.
This setup has several advantages:
- Easy-to-use user interface for classroom learning
- No PC required, reducing equipment costs and space requirements in a classroom
- Increased flexibility as less bench space is needed
- Students can observe the live image, record images on an SD card, or measure images with variety of annotations
| EP50 Camera Spesifications | ||
| Image Sensor | Color CMOS | |
| Sensor Size | 1/1.8 inch (7.140 mm × 4.980 mm) | |
| Resolution (max.) | 2592 × 1944 pixels (Snapshot only) 1920 × 1080 pixels (HDMI, WLAN, on PC) |
|
| Pixel Size | 2.4 × 2.4 μm | |
| A/d Converter (Bit Depth) | 8 bits | |
| Exposure Times | 1 ms – 918 ms | |
| Live Frame Rates | Snapshot only (2592 × 1944 pixels) Up to 30 fps (on PC, 1920 × 1080 pixels) Up to 60 fps (HDMI Output, 1920 × 1080 pixels) Up to 25 fps (WLAN Output, 1920 × 1080 pixels) |
|
| Data Transfer | HDMI, WLAN (using the WLAN adaptor), Ethernet (using the USB-to-Ethernet adaptor) |
|
| Annotation Functions | Text, Arrow, Rectangle, Circle | |
| Measurement Functions | Line: Length measurement Parallel lines Circle: Diameter, area, perimeter measurement Angle: Angle measurement Rectangle: Area, perimeter measurement Polygon: Area, perimeter measurement Point: Coordinates, number Scale bar |
|
| Remarks | Support Mobile Device OS: EPView is available for | |
| iOS 11 and later | Android 5.1 and later | |
| |
|
|
| Supported number of connections to one camera: 6 | ||
| WLAN adaptor not included. Please contact your local sales representative. | ||
| PC Control | Microsoft Windows 10 (32 bit/64 bit) Microsoft Windows 8/8.1 (32 bit/64 bit) Microsoft Windows 7 (32 bit/64 bit) |
|
| Dimensions (W × D × H) | 78 mm × 65 mm × 88 mm (3.08 in. × 2.56 in. × 3.47 in.) | |
| Weight | Approx. 470 g (1.04 lb) | |
| Camera Mount | C-mount | |
| Storage | SD (HC I; UHS-I, Class 10) Card | |
For other products from Evident-Olympus, click here.